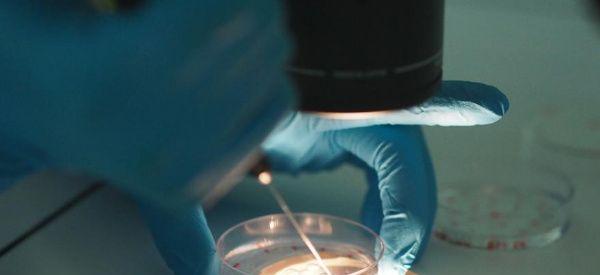
私立医院做试管靠谱嘛？做个试管男婴儿要多少钱？

-

儿童益智玩具手工制作(如何用纸杯做个益智玩具)
有时候家中给娃买得玩具多了,摆不下,但又想让娃锻炼手眼协调能力,找了许久,终于找到这款DIY剑玉,分享给大家。剑玉是一种源于日本的民间游戏,也是现在全世界都有不少..
2022-11-17 09:17 -

怎样做个好家长?
1、爱的表达源于父母的一个溫柔的相拥、一点点激励、赏析、赞成乃至仅仅一个小小笑容对孩子自信心的创建都拥有不可忽视的危害。殊不知,许多父母却吝于向孩子表述这一切,..
2023-01-11 14:00 -

怎样与人处好人际关系 学起来,做个受欢迎的人!
怎样与人处好人际关系?处处讲究人际关系,生活、工作等等,好的人际关系会我们带来好的机遇,而人际关系若是处理不好,那么会给自己带来麻烦,特别是在工作中。因此,大家..
2023-03-29 23:54 -

谨记如何预防葡萄胎 做个健康幸福准妈妈
如何预防葡萄胎?临床诊断葡萄胎皆是指完全性葡萄胎而言,部分葡萄胎伴有胎盘组织或/及胎儿者,则冠以部分性葡萄胎。在自然流产的组织中发现40%病人有一定的水泡样变性,但..
2023-05-02 07:23 -

半夜做个噩梦醒来冷到发抖 惊悚小说正在摧毁青少年
现在的孩子已经不像以前那样缺少这个或者是缺少那个的了,什么手机、平板的已经玩得比大人都还要溜了。但是也有的孩子是比较喜欢读书的,喜欢看一些爱情或者是恐怖的小说,..
2023-07-14 09:15 -
如何在婆家做个聪明女人,越早学会越享自由
虽然许多女人都明白,如果可以尽量不要跟婆家住在一起,但现实往往不尽如人意,有的是因为传统的家庭观念,有的则是屈服于高昂的房价。不管是因为什么原因,如果女人不得不..
2024-01-02 12:20 -
私立医院做试管靠谱嘛?做个试管男婴儿要多少钱?
私立医院做试管靠谱嘛?做个试管男婴儿要多少钱?随着试管婴儿技术的不断发展,越来越多的夫妇寻求这一生育途径,而其中的一个问题就是在私立医院进行试管婴儿是否靠谱,以..
2024-01-11 09:19 -

长沙试管婴儿做个男宝宝的费用是多少钱?详细解析基本费用!
长沙试管婴儿做个男宝宝的费用是多少钱?详细解析基本费用!长沙试管婴儿做个男宝宝的费用大概在8-12万元之间,但具体费用还需根据患者的具体情况和选择的治疗方案而定。为..
2024-02-18 09:00 -

试管做个男宝多少钱?附试管费用明细?
试管做个男宝多少钱?附试管费用明细?很多朋友都知道可以生或者女生,但是不知道要花多少钱,去哪里做。我们来看看试管婴儿做一个试管婴儿要多少钱。试管男婴贵吗?很多朋..
2024-03-30 09:04 -

两个女的试管能生孩子么?做个男孩费用要多少钱?
两个女的试管能生孩子么?做个男孩费用要多少钱?随着科技的不断进步,试管婴儿技术为无法自然怀孕的夫妇提供了一种实现生育梦想的选择。然而,有些人可能想知道,两个女性..
2024-04-28 09:25 -

做个试管男宝需要多少钱?总费用一般在15万元以上!
做个试管男宝需要多少钱?总费用一般在15万元以上!随着生育率的下降,试管婴儿技术也受到了越来越多的关注。然而,有很多人不了解试管婴儿的技术,也不清楚做一个试管宝宝..
2024-05-18 09:00 -

试管做个男宝多少钱?试管生男宝费用高吗?
试管做个男宝多少钱?试管生男宝费用高吗?很多朋友都知道试管婴儿可以选择男孩或者女孩,但是不知道要花多少钱,去哪里做。看看试管婴儿生男孩要多少钱,在哪里可以做。一..
2024-07-16 09:29 -

招财符刺青,做个好运人生
招财符刺青,做个好运人生想要让自己的人生越来越好,招财符刺青或许是一个不错的选择作为一个古老的传统文化符号,招财符早就被人们视为神奇的物品,它蕴含的招财运势更是备受..
2024-07-17 23:53 -

试管移植前做个三维b超发现子宫畸形,这咋办
“试管移植前做个三维b超发现子宫畸形,这咋办?还能移植吗?”这是今天早上一个亲戚来电咨询的问题,我认为发表出来应该对其他同病症患者也有帮助,所以整理了一下相关答..
2025-05-03 10:07 -

43岁女性去北京做个供卵试管自怀需要多少钱?
43岁女性去北京做个供卵试管自怀需要多少钱?我现在43岁,有多年不孕病史。二十多岁的时候,医生说我有。我有三个试管,但是都因为各种原因失败了。现在只想有供卵试管的自..
2025-06-13 09:18 -
兰州兰大一院做个三代试管婴儿多少钱?
本人兰州的,我第一胎左侧输卵管宫外孕,第二胎停育,去医院检查出来输卵管堵塞,羊角子宫。不想再重蹈覆辙就打算做试管了,听说兰大一院还不错,试管成功率还比较高。就想..
2025-06-26 11:07 -
[做试管要多久]做个三代试管婴儿多长时间?不孕不育患者来看!
三代试管婴儿技术发展以来,让更多不孕不育的夫妻有了做父母的机会,这也让其他的患者看到了希望,但是很多人想知道的是做个三代试管婴儿多长时间?[做试管婴儿要多久]做个..
2025-08-22 11:14 -
做个三代试管婴儿大概花多少钱[三代试管婴儿有什么好处]
做个三代试管婴儿大概花多少钱[三代试管婴儿有什么好处]。现在很多人都很重视三代试管婴儿的手术,这个手术给很多家庭都带来了希望,可以带来的好处非常多,是很值得信任的..
2025-09-02 09:41 -

爱情和合术 挽回你的爱情做个尝试
我们来世间走一遭,想拥有的很多,爱情、友情、亲情、金钱、权利、荣誉……我们想要的很多,但不一定都会得到,真正能够拥有的又很少。我们想要拥有爱情,我们已经拥有爱情..
2025-10-09 18:41
微信分享
扫描二维码分享到微信或朋友圈